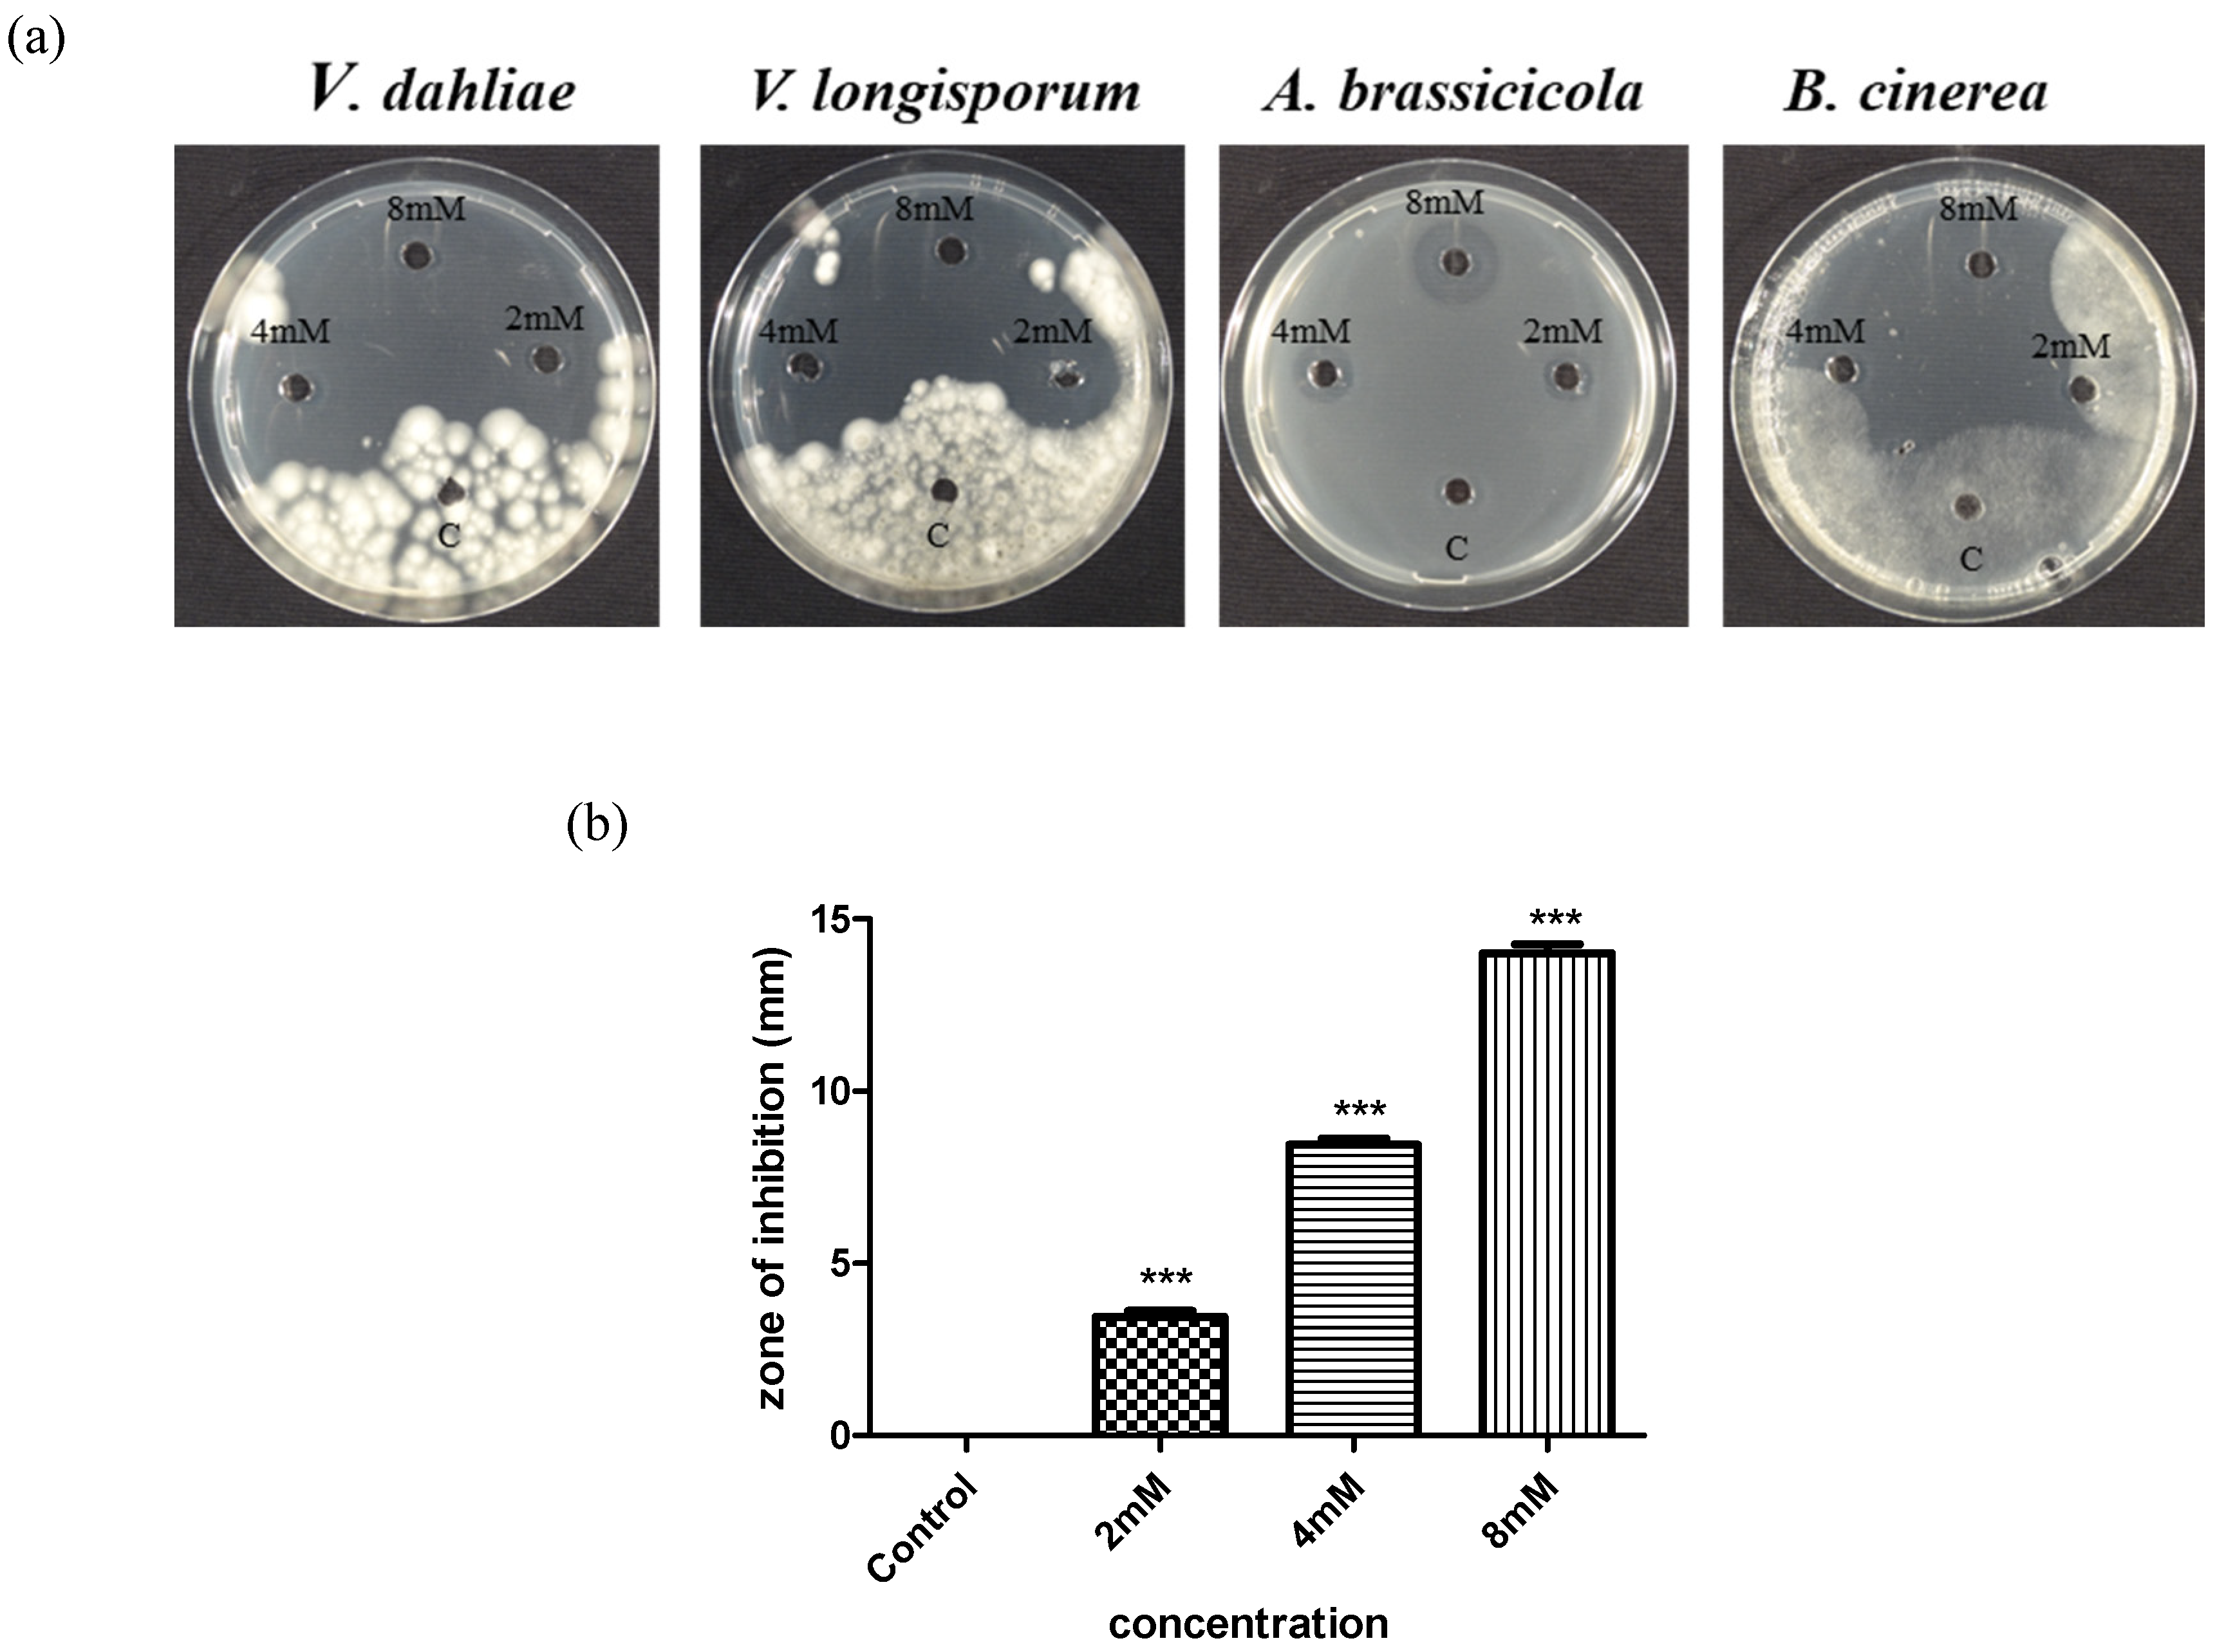

Fungi Dna Extractio From Agad
Ad We offer kits for extracting DNA from plants as well as fungal DNA isolation kits. Nucleic Acid Reagents Nucleic Acid Purification Kits and Reagents.
Applied Sciences Free Full Text Efficacy Of Allicin Against Plant Pathogenic Fungi And Unveiling The Underlying Mode Of Action Employing Yeast Based Chemogenetic Profiling Approach Html
The procedure is easy and can be completed in minutes.

Fungi dna extractio from agad. To assess the antimicrobial potential of the mar-ine fungi. An Easy Rapid and Cost-Effective Method for DNA Extraction from Various Lichen Taxa and Specimens Suitable for Analysis of Fungal and Algal Strains. Ad We offer kits for extracting DNA from plants as well as fungal DNA isolation kits.
Historically extraction of usable nucleic acids from plants and fungi has been difficult in some instances notoriously so. Check out our kits for purifying genomic DNA from a variety of sources including tissue blood plasma plants soil food formalin-fixed paraffin-embedded FFPE samples forensic samples and cell lysates. Streamlined optimized DNA extraction protocols simplify handling.
Cetyltrimethylammonium bromide CTAB buffer is used for DNA extraction. To isolate marine fungi from sponges and brown algae collected around Mauritius 2. DNA extraction DNA extraction was conducted by the following modification method of Atashpaz et al.
Total DNA including genomic DNA mitochondrial DNA and chloroplast DNA can be purified from fresh or frozen plant tissues plant cells or filamentous fungi. Streamlined optimized DNA extraction protocols simplify handling. Asked 20th Nov 2016 in the project PCRDNA extraction from fungi and algae.
In general success in DNA extraction is measured by DNA. Here we have used CTAB for DNA extraction not only from plants but various other samples like FUNGI ALGAE. These procedures have been used successfully for isolation of genomic DNA from Aspergillus and Candida species from both fungal.
Long DNA it is important to start with sample types compatible with high molecular weight DNA extraction. Fungal mycelia or 23 colonies of yeast were taken in. Ministry of Science and Technology Iraq.
A universal DNA extraction and PCR amplification method for fungal rDNA sequence-based identification A. Most of the protocols currently used for DNA extraction from Prototheca algae are essentially the same as those applied for plants andor fungi and usually exploit a variety of. Up to 10 cash back In detail 5 μL of each DNA extract was analyzed in a 15 agarose gel stained with 05 Midori Green Nippon run in 1 TAE buffer.
BioBasic kits can be used for DNA isolation from blood plant tissue mammalian cells and tissue bacteria and fungi. A Rapid and Reproducible Genomic DNA Extraction Protocol for Sequence-Based Identification of Archaea Bacteria Cyanobacteria Diatoms Fungi and Green Algae September 2016 Authors. Ad Extract high-quality DNA w excellent reproducibility for molecular biology experiments.
Once the fungus was grown in the SDA media for 24 hours its cell biomass was. Isolation of genomic DNA from fungi culture and blood using the QIAamp DNA Mini Kit - EN Print Bookmark Share. Formerly used in our laboratory for extraction of DNA from Mycobacterium tuberculosis.
Pombe as well as Gram - bacteria algae and protozoa. Cetyltrimethylammonium bromide CTAB buffer is used for DNA extraction from plants with various other extraction buffers. Romanelli Department of Pathology and Laboratory.
Almost all methods to extract nucleic acids must be performed in a laboratory eg18Many systematic phylogenetic molecular and related studies of plants and fungi utilize DNA andor RNA as a primary source of data914In most instances fresh tissues are used for extraction. These fast easy-to-use kits provide pure high-quality genomic DNA. DNA Isolation BioBasic.
Ad Extract high-quality DNA w excellent reproducibility for molecular biology experiments. Genomic DNA Isolation from Fungi Algae Plant Bacteria and Human Blood using CTAB. The Quick-DNA FungalBacterial kits are designed for the simple and rapid isolation of DNA from tough-to-lyse fungi including A.
DNA isolation with good intensity and quality is always been a necessity whether you need for PCR or any other analysis. - Fungi - microorganisms mushrooms algae - Plants - broad leaf plants grasses Algae is included with fungi due to similar growth and storage conditions. To identify the marine fungi based on the Internal Transcribed Spacer ITS regions of the ribosomal DNA and phylogenetic analyses 3.
CTAB is mainly used in extraction of DNA from plants species. Mritunjay Singh Kumar Gurneet Kaur Avneet Kaur Sandhu. PCI method of DNA extraction.
The Soil DNA Extraction Kit was designed for rapid isolation of genomic DNA from microorganisms such as bacteria archaea fungi. Norgen Bioteks PlantFungi DNA Isolation Kit provides a rapid method for the isolation and purification of total DNA from a wide range of plant and filamentous fungal species. These kits include animal tissue fungi genomic DNA extraction prep kit Bacteria genomic DNA prep kit Blood genomic DNA prep kit Plant genomic DNA prep kit Yeast genomic DNA extraction prep Kit.
Up to 10 cash back Abstract.

Penicillium Excelsum A New Species Of Fungi From The Brazil Nut Tree Ecosystem In The Amazon Basin Microbiology Microbiology Lab Medical Laboratory Science

Fungal Dna Virus Infects A Mycophagous Insect And Utilizes It As A Transmission Vector Pnas

Screening A And Isolation B C Of Yeasts On Ygc Agar Medium With Download Scientific Diagram

Rhodotorula Rubra Basidiomycota On Sabouraud Dextrose Agar Microbiology Petri Dishes Science And Nature
Komentar
Posting Komentar